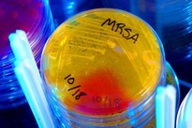
Phát hiện kháng sinh mạnh gấp 100 lần, mang hy vọng mới cho y học

Con bị dị tật tim bẩm sinh – mẹ có thể mắc bệnh tim
(Dân trí) - Những bà mẹ có con bị dị tật tim bẩm sinh có nguy cơ phải nhập viện do bệnh tim những năm sau này.
Tiến sĩ Nathalie Auger thuộc Bệnh viện Đại học Montreal, Canada, cho biết “có con bị dị tật tim là một dấu hiệu người mẹ cũng có nguy cơ mắc bệnh tim.” Các nghiên cứu trước đây đã phát hiện ra rằng những bà mẹ sinh con có dị tật dưới bất kì dạng nào đều có nguy cơ tuổi thọ kém hơn những người khác.

Theo Viện tim, phổi và huyết học quốc gia (Canada), những bất thường về cấu trúc của tim là nguyên nhân phổ biến của dị tật bẩm sinh và trong mỗi 1.000 trẻ sơ sinh thì có 8 trẻ có dị tật ở tim. Trong nghiên cứu của mình, Tiến sĩ Auger và đồng nghiệp kiểm tra gần 1,1 triệu phụ nữ ở Quebec sinh con trong thời gian từ năm 1989 đến 2013 và nhận thấy 1.516 trẻ sơ sinh bị dị tật tim nghiêm trọng, 14.884 trẻ bị dị tật nhẹ. Dị tật nghiêm trọng cần được chữa trị sớm sau khi sinh, còn dị tật nhẹ có thể điều trị sau này hoặc không cần điều trị.
Quá trình theo dõi các trường hợp này kéo dài 25 năm kể từ khi các bà mẹ bắt đầu mang thai. Những phụ nữ có con bị dị tật tim nặng có nguy cơ phải nhập viện do bệnh lí tim mạch cao hơn 43%; và phụ nữ có con bị dị tật tim nhẹ thì nguy cơ cao hơn 24% so với các bà mẹ không có con bị bệnh tim. Mẹ sinh con bị bệnh tim nặng có nguy cơ gấp đôi sẽ gặp các cơn đau tim, nguy cơ gấp 3 lần mắc các bệnh do xơ cứng động mạch, và nguy cơ gấp 40 lần cần được ghép tim; còn mẹ sinh con có bệnh nhẹ thì các nguy cơ suy tim, mắc bệnh động mạch phổi hoặc cần lắp máy trợ tim cap gấp đôi so với mẹ sinh con không mắc bệnh.
Mặc dù nghiên cứu không đi sâu tìm hiểu nguyên nhân vì sao dị tật tim ở trẻ lại liên quan đến bệnh tim của mẹ, nhưng các tác giả nhấn mạnh rằng những cặp mẹ con này đều có chung các yếu tố gây nguy cơ, chẳng hạn như người mẹ hút thuốc lá. Ngoài ra, do sinh con bị bệnh, người mẹ dễ bị căng thẳng, trầm cảm khiến nguy cơ bệnh tật càng tăng cao.
Nhìn nhận một cách tích cực, tiến sĩ Auger cho rằng “Đây là một cơ hội lớn mà nam giới không có được như phụ nữ. Mang thai thực sự là một thời gian quí báu để phát hiện ra những mối liên hệ với sức khỏe sau này của bạn, cho phép bạn thay đổi ngay từ bây giờ hơn là sau này, biết đâu khi đó lại là quá muộn để cải thiện sức khỏe của mình. Khi đứa con vừa sinh ra đã có dị tật tim, người mẹ nên sớm tạo ngay cho mình những thói quen sinh hoạt lành mạnh để bảo vệ trái tim của chính mình, như là bỏ hút thuốc, tập thể dục và có chế độ ăn hợp lí”.
Phạm Hường (Theo RT)